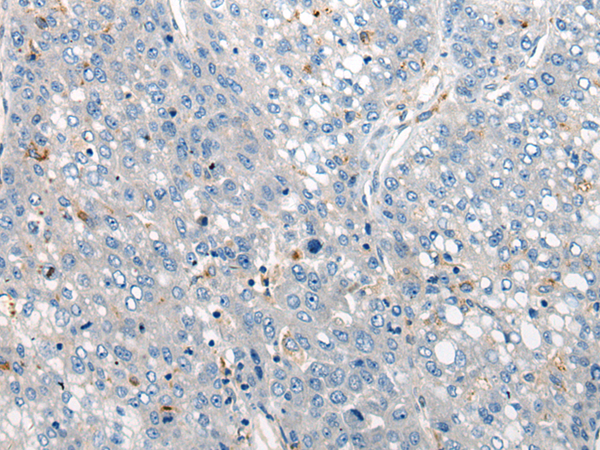
一抗

中文名稱:兔抗CLCNKA多克隆抗體
|
Background: |
This gene is a member of the CLC family of voltage-gated chloride channels. The encoded protein is predicted to have 12 transmembrane domains, and requires a beta subunit called barttin to form a functional channel. It is thought to function in salt reabsorption in the kidney and potassium recycling in the inner ear. The gene is highly similar to CLCNKB, which is located 10 kb downstream from this gene. Multiple transcript variants encoding different isoforms have been found for this gene. |
|
Applications: |
ELISA, IHC |
|
Name of antibody: |
CLCNKA |
|
Immunogen: |
Synthetic peptide of human CLCNKA |
|
Full name: |
chloride voltage-gated channel Ka |
|
Synonyms: |
CLCK1; ClC-K1; hClC-Ka |
|
SwissProt: |
P51800 |
|
ELISA Recommended dilution: |
5000-10000 |
|
IHC positive control: |
Human liver cancer |
|
IHC Recommend dilution: |
20-100 |

 購物車
購物車 幫助
幫助
 021-54845833/15800441009
021-54845833/15800441009